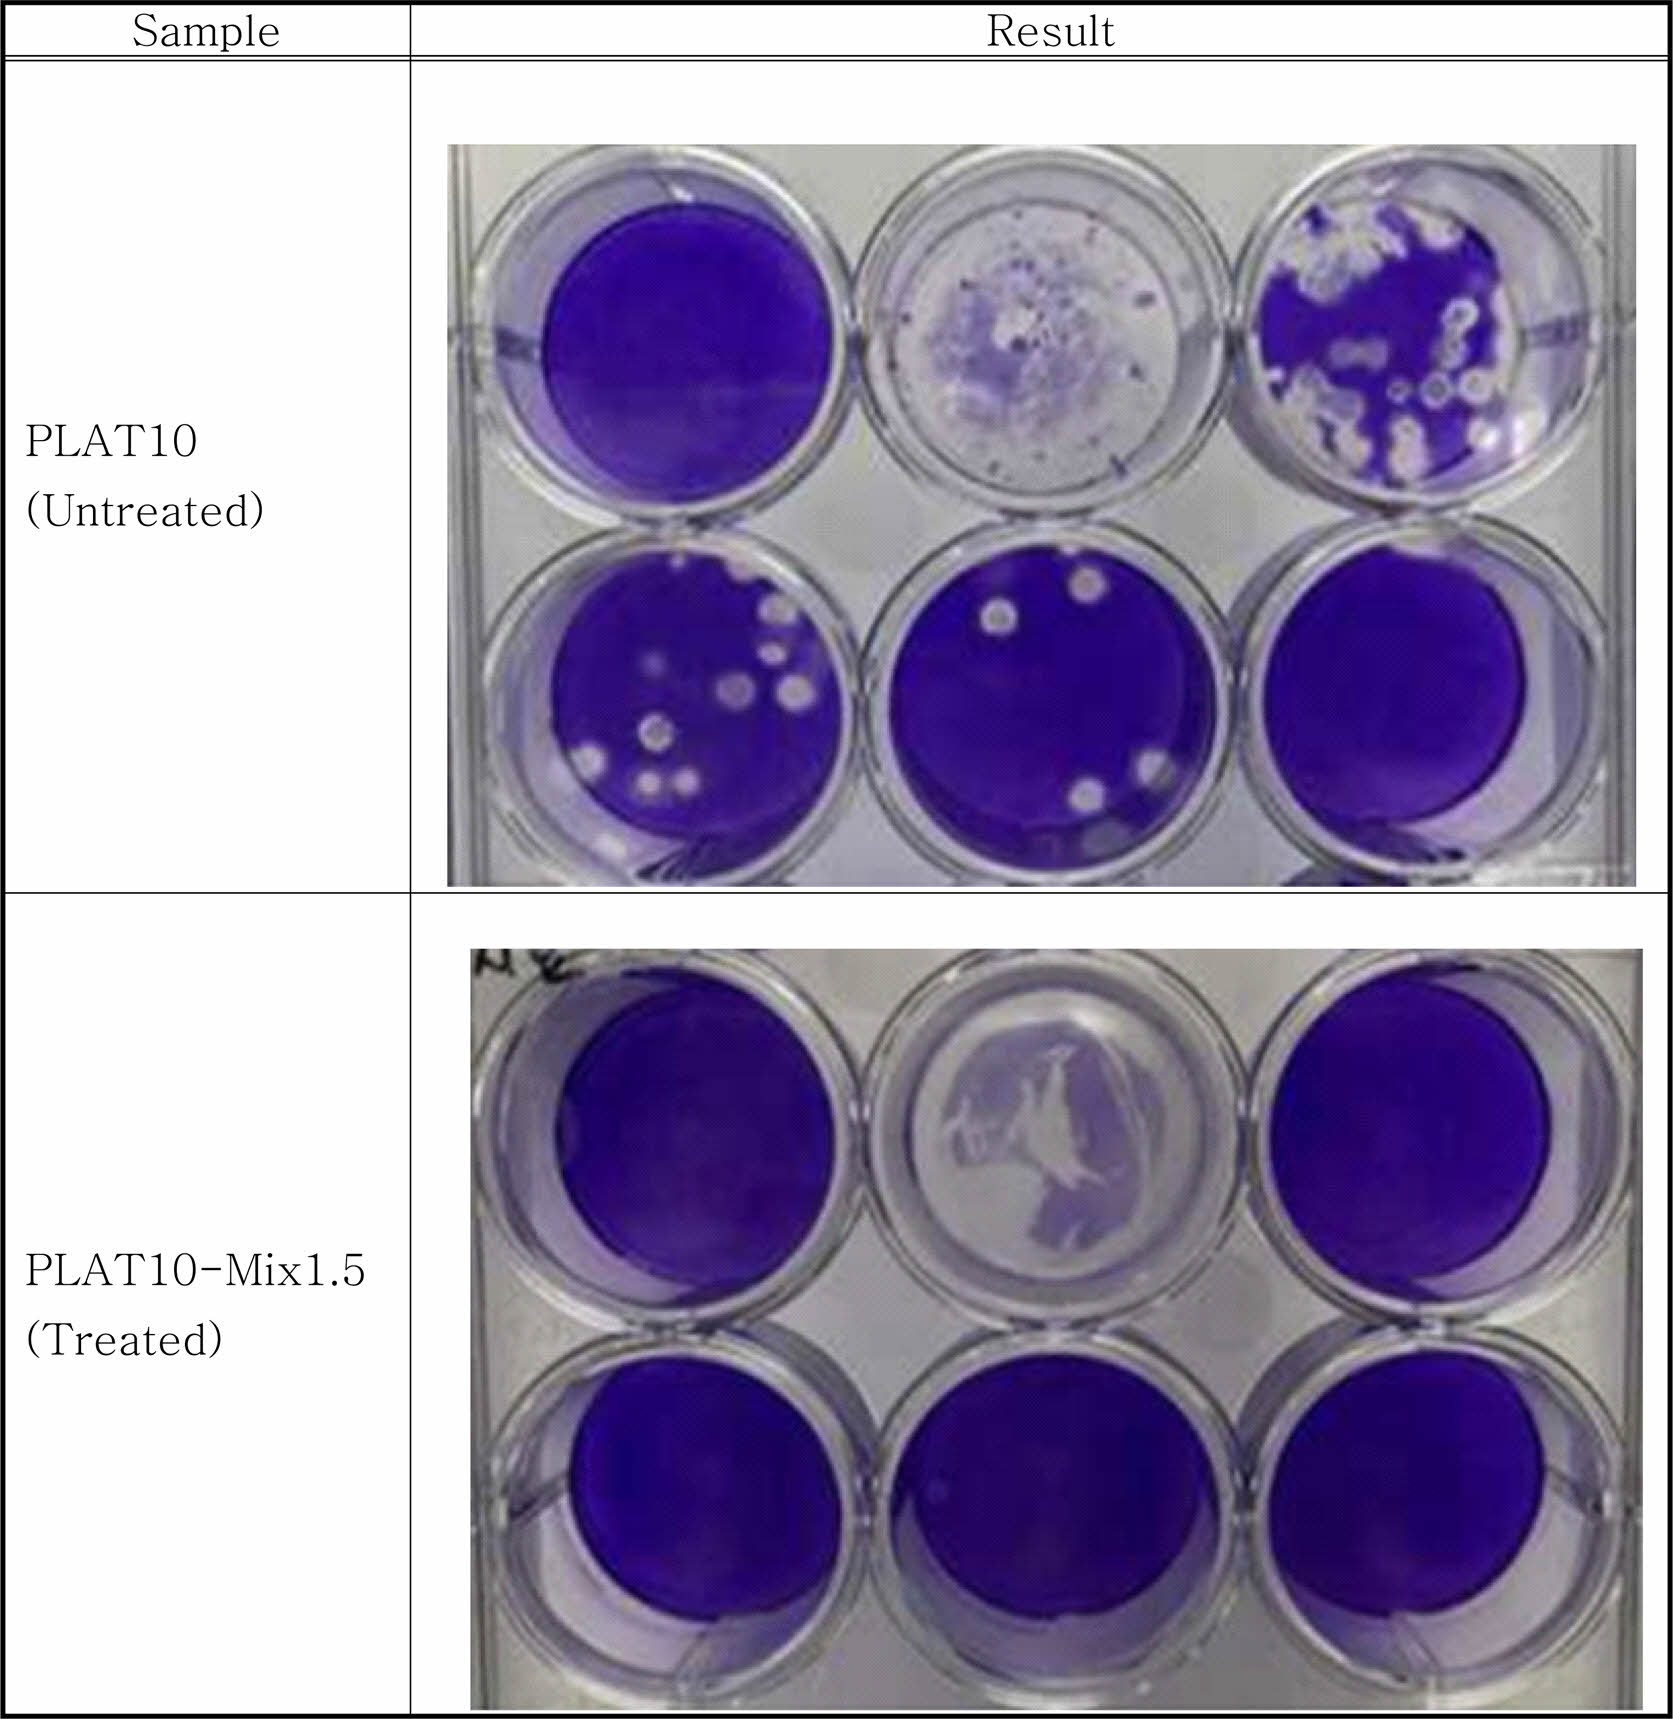

- Thermal and Mechanical Properties of Antimicrobial Poly(lactic acid) Composites
Department of Chemical Engineering, Kunsan National University, Daehakro 558, Kunsan, Chonbuk 54150, Korea
*Bestech Incorporated Co., Dongkunsanro 942, Seosumyeon, Kunsan, Chonbuk 54051, Korea- 항균 폴리유산 복합재료의 열적 및 기계적 물성
군산대학교 공과대학 화학공학과, *(주)베스텍
Reproduction, stored in a retrieval system, or transmitted in any form of any part of this publication is permitted only by written permission from the Polymer Society of Korea.
Antimicrobial plastics containing benzalkonium chloride, 1,2-hexanediol/1,2-octanediol 1:1 mixture, and copper sulfide (CuS) powder biocides added alone or all together to a poly(lactic acid) composite containing 10 wt% of talc were manufactured by a twin-screw extruder and were injected into specimens for physical properties. In the both cases including the 1:1 mixture of 1,2-hexanediol and 1,2-octanediol or all three biocides, the heat resistance of the antibmicrobial poly(lactic acid) composite was slightly decreased. However, both benzalkonium chloride and copper sulfide showed its some improvement. Although the tensile strength didn’t change by the addition of biocide, the tensile modulus was slightly decreased and the elongation at break was greatly decreased. Flexural strength also decreased with the addition of biocide, but flexural modulus slightly increased. Notched Izod impact strength showed a tendency to decrease with a slight difference depending on the biocide. The antibacterial performance was excellent in the cases containing benzalkonium chloride, but was poor in those containing the 1,2-alkanediol mixture or copper sulfide. The antifungal performance was the best when all three biocides were added, rather than those used alone. The sterilizing power of influenza A virus was excellent as 99.998% when all three were added. Mixing biocides showed a synergistic effect on the antimicrobial performance of poly(lactic acid) composites, but more efforts such as evaluating the effects of biocides on the human body are expected to contribute to securing the stability of poly(lactic acid) products.
탈크를 10 wt% 포함하는 폴리유산 복합재료에 살생제로 벤잘코늄염화물, 1,2-헥산디올과 1,2-옥탄디올 1:1 혼합물 및 황화구리(CuS) 분말을 단독 또는 혼합 첨가한 항균 플라스틱을 이축 압출기로 제조하였고 물성 시편으로 사출하였다. 1,2-헥산디올과 1,2-옥탄디올 1:1 혼합물과 3가지를 모두 포함하는 경우에서 항균 폴리유산 복합재료의 내열성은 약간 감소하였으나 벤잘코늄염화물과 황화구리는 약간 상승시켰다. 살생제 첨가에 의해 인장강도는 거의 변하지 않았으나 인장탄성률은 약간 감소하였고 신율은 크게 감소하였다. 살생제 첨가로 굴곡강도는 감소하였고 굴곡탄성률은 약간 증가하였다. 노치드 Izod 충격강도는 살생제에 따라 약간의 차이는 있지만 모두 감소하였다. 항박테리아 성능은 벤잘코늄염화물을 포함하는 경우들에서 우수하였으나 1,2-알칸디올 혼합물 또는 황화구리를 포함한 폴리유산 복합재료에서는 나빴다. 항진균 성능은 살생제를 단독 사용한 것들 보다 세 가지 모두 첨가한 경우가 가장 우수하였다. 인플루엔자 A 바이러스의 살균력도 세 가지 모두 첨가한 경우가 99.998%로 우수하였다. 본 연구에선 살생제를 혼합하여 폴리유산 복합재료의 항균성능에서 상승효과를 보였으나 인체에 대한 영향 평가 등 보다 많은 노력이 플라스틱 제품의 안정성 확보에 기여할 것으로 판단된다.
Antimicrobial plastic containing benzalkonium chloride, 1,2-hexanediol/1,2-octanediol 1:1 mixture, and copper sulfide (CuS) powder biocides added all together to a poly(lactic acid) composite containing 10 wt% of talc was manufactured by a twin-screw extruder and was injected into specimens for physical properties. This plastic showed antibacterial, antifungal, and antiviral activities.

Keywords: poly(lactic acid), benzalkonium chloride, 1,2-alkanediols, copper sulfide, antimicrbial activity.
이 논문은 (재)전북테크노파크의 2021년도 전라북도 혁신성장 R&D+ 지원 사업으로 수행된 연구임.
저자들은 이해상충이 없음을 선언합니다.
플라스틱 쓰레기에 대한 환경 문제를 해결하기 위한 방법으로 생분해성 고분자에 대한 관심이 증가하고 있다. 생분해성 고분자로 폴리유산(poly(lactic acid), PLA)은 옥수수 전분 발효로 얻어지는 유산(alctic acid) 또는 락타이드(lactide)를 중합하여 얻어지므로 지속가능한 생물 유래 고분자이며 대량생산 시설 투자를 통해 가격을 낮추려 노력하고 있다.1 폴리유산은 투명하고 기계적 물성은 우수하나 비교적 낮은 내열성과 높은 취성을 갖고 퇴비 환경(60 oC)이 아닌 자연환경에서는 생분해 속도가 느리며 아직도 높은 가격으로 인해 상용화에 어려움이 있다.2-7
최근 Covid-19의 팬더믹 상황에서 고분자에 살생제(biocides)를 혼합하여 바이러스의 확산을 막으려는 시도가 이루어지고 있고 항바이러스 페인트 및 항바이러스 필름이 개발되어 사용 중에 있다. 폴리유산 또는 폴리유산 블렌드에 살생제를 첨가하여 음식물 포장용 필름, 3D 프린팅(additive manufacturing), 약물전달시스템(drug delivery system) 등에 적용하기 위한 연구로는 무기물로 ZnO 나노입자가5,8 대표적이며 TiO2,9 ZrO2,10 Ag(나노입자 또는 AgNO3)7,11,12 또는 Cu 나노입자12 등을 사용한 바 있다. 유기물 또는 천연물 단독으로 사용한 것으로 리그닌(lignin),2 티몰(thymol),13,14 카르본(R-carvone),14 키토산(chitosan),3,15,16 계피산(cinnamic acid) 또는 페룰산(ferulic acid),17 카바크롤(carvacrol),18 차조기 유(perilla essential oil),19 HPQM(2-hydroxypropyl-3-piperazinyl-quinoline carboxylic acid methacrylate),4 케토코나졸(ketoconazole),20 반코마이신(vancomycin)21 등이 있고 주로 항박테리아(anti- bacterial) 또는 항진균(antifungal) 능력을 보였다. 살생제로 두 가지 이상을 폴리유산에 첨가한 경우는 키토산과 1,2-benzisothiazoline-3-one(BIT),22 또는 리그닌, ZnO와 질산은(AgNO3)을 모두 사용한 연구가6 있다.
본 연구에서는 항균 폴리유산을 만들기 위해 살생제로 벤잘코늄염화물(benzalkonium chloride), 1,2-알칸디올(alkanediols) 및 황화구리(CuS)를 단독 또는 혼합하여 사용하였다. 벤잘코늄염화물은 2020년 5월 환경부 화학제품관리과에서 코로나19 살균 소독제 유효성분으로 유효농도는 0.05-0.5%로 공표한 바 있다. 벤잘코늄염화물은 8-18 사이의 다양한 짝수 알킬 그룹을 갖는 알킬벤질디메틸암모늄 염화물로 4급 암모늄화합물(quaternary ammonium compound)에 속하고 살생제,23-25 양이온 계면활성제26 등으로 사용중이다. 벤잘코늄염화물은 항박테리아, 항진균 및 항바이러스 성능이 우수하여 점안액, 가글, 손세정제, 일반 소독제, 코로나 바이러스 소독제 등으로 사용된다.23,25 벤잘코늄염화물은 충치 치료 시 충진제로 사용되는 4-methacryloyloxyethyl trimellitate anhydride/methyl methacrylate-tri-n-butylborane(4-META/MMA-TBB) 수지로 Bondfill SB Plus monomer 제품, 제조사는 Sun Medical Co. Ltd.(일본)에 2.5 wt% 이상 첨가 시 충치균 3종의 성장을 상당히 저해하였다. 그러나, 3-점 굴곡강도 및 뿌리 상아질에 대한 전단 접착 강도는 벤잘코늄염화물 첨가 시 약간 감소하였다.23
1,2-알칸디올은 주로 화장품에 사용되는 보존제(preservative)로 기존의 파라벤을 대체하여 항박테리아 및 항진균(이스트와 곰팡이) 성능이 뛰어나다.27-29 액체 배지에서 시험한 결과 페녹시에탄올, 1,2-옥탄디올, 1,2-헥산디올 또는 1,2-펜탄디올을 단독으로 첨가 배양한 경우 Escherichia coli와 Pseudomonas aeruginosa 박테리아에 대해 모두 1,2-옥탄디올이 순서대로 0.2% 이상 및 0.3% 이상에서 가장 우수한 억제효과를 보였다.28 Staphylococcu. aureus 박테리아도 1,2-옥탄디올이 가장 우수하였으나 0.3%(실험 시 최대 농도)에서도 효과적으로 균 성장을 억제하지 못했고 진균인 Candida albicans의 경우에는 가장 우수한 1,2-옥탄디올도 0.3%에서 억제 효과가 낮았다.28 페녹시에탄올, 1,2-옥탄디올 및 1,2-헥산디올을 혼합하여 사용하는 것이 가장 우수하였고 1,2-옥탄디올 및 1,2-헥산디올만을 혼합하여 사용하는 것도 우수한 항박테리아 및 항진균 성능을 보였다.27,28 1,2-알칸디올은 미생물의 세포벽 형성을 방해하여 이들의 성장을 막는 것으로 알려져 있다.30
황화구리(CuS) 나노입자31,32 또는 구리화합물(CuO, Cu2O 등)은33 항박테리아, 항조류 및 항바이러스 성능을 갖고 있어 페인트 및 포장 필름에 적용되고 있다. 최근 노루페인트가 구리함유 유리인 미국 코닝사의 항바이러스 항세균 코닝 가디언트(corning guradiant)를 이용하여 피막 및 비피막 바이러스, 습식과 건조 상태 모두에서 사멸효과가 뛰어나고 코로나19 바이러스를 직접 시험한 결과 페인트 접촉 후 30분내 99.4%가 사멸하는 결과를 얻었다. 이 화합물들은 Cu+ 또는 Cu2+ 이온을 방출하여 미생물과 조류 등의 세포벽을 파괴하거나 변화시켜 세포질이 방출되어 사멸되는 것으로 알려져 있다.33
자체가 항바이러스성인 고분자(antiviral polymer)는 황산화된 다당류(sulfated polysacccharides), 덱스트란 황산염(dextran sulfate), 헤파린 등의 음이온 고분자로 체내에서(in vivo) HIV의 강력한 저해제(inhibitor)로 보고되었다.34 약물과 고분자의 콘쥬게이트(conjugate)로 항바이러스 의약인 AZT(azido-3'-deoxythymidine)를 κ-카라기난(κ-carrageenan)에 콘쥬게이트시킨 것은 다당류보다 HIV에 대해 100배 더 활성이 컸다. 이밖에도 고분자-약물 덴드리머와 생체모방 고분자 등이 있다. 시알산(sialic acid)을 포함하는 고분자는 인플루엔자(influenza) 바이러스의 hemagglutinin(HA) 스파이크에 달라붙어 세포에 부착하는 것을 막을 수 있다.34
코로나 바이러스(Covid-19)는 감염자의 침과 콧물 등의 비말이 직접 접촉에 의해 주로 감염되지만 이 비말이 묻은 표면과의 접촉으로도 감염될 수 있다. 따라서, 여러 사람이 접촉하는 손잡이, 엘리베이터 버튼, PC방 컴퓨터, 공중전화, 탁자 등의 표면은 항바이러스 페인트로 코팅하거나 항바이러스 플라스틱으로 제조하는 것이 향후 바이러스 질병의 전국적인 유행을 막는 데 도움이 될 것이다. SARS-CoV-1 바이러스(인간 코로나 바이러스와 유사)는 플라스틱 표면에서 4-5일간 생존할 수 있고 SARS-CoV-2 바이러스(중국 우한 바이러스)의 반감기는 플라스틱 표면에서 약 6.8시간으로 스테인레스 스틸(5.6시간)보다 길었다.35 따라서, 코로나 바이러스를 막기 위해 항바이러스 플라스틱 컴파운드, 항바이러스 고분자, 금속(Au, Ag, Al, Cu, Fe2O, ZnO, MgO 및 TiO2가 항바이러스 성능 보유) 표면 코팅, 나노질감(nanotexturing) 등의 응용이 요구된다.36
본 연구는 세 가지 살생제를 고분자에 조합한 연구로 단독 성분 및 혼합 사용 시 압출 및 사출 가공으로 얻어진 항균(antimicrobial) 폴리유산 복합재료의 내열성(TGA), 결정화도(DSC), 기계적 물성(인장 및 굴곡 특성) 및 충격강도 변화와 항박테리아, 항진균 및 항바이러스 성능을 조사하였다. 본 연구를 통해 항균성이 우수하면서도 열적 및 기계적 물성의 감소를 최소화 하는 방안을 찾고자 하였다.
재료. 폴리유산은 ㈜안코르에서 생산 판매하는 사출용 그래이드 BG4400G(밀도 1.38 g/cm3, Melt Flow Index(190 oC, 2.16 kg) 5-12)를 구입하여 사용하였고 벤잘코늄염화물은 ㈜대정화금(한국), 1,2-헥산디올 및 1,2-옥탄디올은 ㈜비앤비(한국), 황화구리(100 mesh powder)는 알드리치(미국)에서 구입한 것을 그대로 사용하였다.
압출 가공 시 안정제로 1차 산화방지제(Songnox 1010) 및 2차 산화방지제(Songnox 1680)의 1:2 블렌드인 Songnox 21B(송원산업)를 0.3 wt% 첨가하였다.
제조 방법. 원료 중에서 BG4400G만 60 oC에서 24시간 건조한 것을 사용하여 Table 1에 주어진 조성에 따라 전체 약 1 kg이 되도록 계량한 다음 믹서로 혼합하고 동일방향 회전(co-rotating) 2축 압출기(한국EM 주식회사, STS-25-40-2V)로 최대온도 195 oC에서 150 rpm으로 혼련하였다. 압출된 스트랜드는 수조에서 식힌 다음 펠릿타이저로 펠릿을 만들었다. 펠릿은 80 oC 오븐에서 6시간 동안 건조하여 수분을 충분히 제거한 다음 사출기(대한전선, LDH-75N 75톤)로 최대온도 200 oC에서 시편금형을 이용하여 사출하였다.
물성 시험 방법. Thermogravimetric analysis(TGA) 실험은 미국 TA Instrument사의 Q50 모델을 이용하였으며 25±10 mg의 시료를 Pt 팬에 담아 100 mL/min의 흐름속도의 고순도 질소 분위기하에서 20 oC/min의 승온속도로 40 oC에서 800 oC까지의 온도범위에서 측정하였다.
Differential scanning calorimetry(DSC) 분석은 미국 TA Instrument사의 Q20 모델을 이용하였으며 20±5 mg의 시료를 Al 팬에 담아 80 mL/min의 흐름속도의 고순도 질소 분위기하에서 20 oC/min의 승온속도로 30 oC에서 240 oC까지의 온도범위에서 측정하였다.
기계적 물성으로 인장, 굴곡 및 충격강도를 측정하였다. 인장 및 굴곡시험은 독일 Zwick사의 만능재료시험기(Z2S-SNSS 모델, 25 kN)에 1 kN 로드셀을 사용하여 수행하였다. 인장 물성은 3.2 mm 두께인 3개의 인장 시편을 변형속도 5 mm/min으로 시험하였다(ASTM D638). 굴곡 물성은 6.4 mm 두께의 막대시편을 변형속도 2 mm/min으로 측정하였다(ASTM D790). Notched Izod 충격강도는 ASTM D256에 따라 3.2 mm 두께의 막대시편 6개를 이용하여 측정하였다.
항박테리아 시험 방법. 항균 폴리유산 복합재료에 대한 항박테리아(antibacterial) 시험은 한국건설환경시험연구원(KCL)에 의뢰하여 진탕플라스크법인 KCL-FIR 1002:2021에 따라 시험하였다. 폴리유산 복합재료를 사출기로 가열하여 1 mm 정도의 두께를 갖는 판으로 제조한 다음 1 cm×1 cm 이하의 크기로 잘라 배양액 1 mL당 0.2 g을 넣고 균주를 접종한 다음 초기 블랭크(blank) 농도(A)에 대하여 37.0±0.3 oC에서 24시간 동안 진탕플라스크 배양 후 균주 농도를 측정하여 24시간 후 시험시료 농도(B)를 이용하여 살균감소율((A-B)×100/A)을 구하였다. 균주는 총 3종으로 Escherchia coli ATCC 25922(대장균), Pseudomonas aeruginosa ATCC 15442(녹농균), 및 Staphylococcus aureus ATCC 6538(황색포도상구균)이 사용되었고 초기 접종원 농도는 1.3-2.6×104 CFU/mL이었다.
항진균 시험 방법. 항진균(antifungal) 시험방법은 곰팡이 저항성(4주) 시험방법인 ASTM G21-2015 시험방법에 따라 한국건설환경시험연구원(KCL)에 의뢰하여 평가하였다. 시편은 3.2 mm 두께의 5 cm×5 cm 판상 시편 3개를 곰팡이 5종으로 각각 Aspergillus brasieliensis ATCC 9642, Penicillium funiculosum ATCC 11797, Chaetomium globosum ATCC 6205, Trichoderma virens ATCC 9645, Aureobasidium pullulans ATCC 15233이 혼합된 균주와 29±1 oC, 85% 상대습도에서 4주간 배양한 후 다음에 주어진 0-5 등급으로 판정한다. 0등급은 none(0%), 1등급은 trace of growth(less than 10%), 2등급은 light growth(10 to 30%), 3등급은 medium growth(30 to 60%), 4등급은 heavy growth(60% to complete coverage)를 각각 의미한다.
항바이러스 시험 방법. 항바이러스(antiviral) 시험은 한국의과학연구원에 의뢰하여 수정된 ISO 21702에 따라 3.2 mm 두께의 5 cm×5 cm 판상시편 5개씩을 BG4400G 사출물(untreated, 대조군)과 항균 폴리유산 복합재료 각각에 대해 준비한 다음 MDK 셀을 세포주로 하여 인플루엔자 A 바이러스(Influenza A(H1N1))에 대해 진행하였다. 반응시간은 2시간 또는 4시간이었고 반응온도는 25±1 oC이었다.
열적 물성. 항균 폴리유산 복합재료 제조에 사용된 항균제들과 BG4400G의 TGA 결과를 Figure 1 및 Table 2에 나타내었다. 내열성은 무기화합물인 CuS가 가장 높았고 다음으로 높은 것은 BG4400G이며 1,2-헥산디올이 가장 낮았다. 사출 가공온도가 200 oC에서 1,2-헥산디올(Tb=223.5 oC) 및 1,2-옥탄디올(Tb=243 oC)은 상당부분 남아 있을 것으로 판단하였다. TGA 분석 결과 200 oC 잔류량은 CuS 100 mesh 분말이 99.0%로 내열성이 가장 높았고 벤잘코늄염화물이 93.1%, 1,2-옥탄디올이 58.2%, 1,2-헥산디올이 30.9%로 나타났다. 압출 및 사출과정에서 실제 온도는 세팅 온도 보다 높게 유지되므로 1.2-알칸디올들의 휘발성이 커서 가공 중에 상당량이 증발될 것으로 예상된다. ㈜안코르의 사출용 BG4400G 그레이드는 탈크를 10 wt%(3회 분석한 평균 값) 포함하므로 순수한 폴리유산보다 결정화 속도가 상당히 빨라 약 80초 정도의 사출 주기를 보였다. 폴리유산의 DTG 분해피크온도가 432.8 oC로 순수한 PLA의 332.5-362.5 oC5,19,37 보다 매우 높게 나타난 것은 각기 사용된 폴리유산의 D, L 이성질체 함량 등이 다르고 탈크에 의한 보호 효과에 의한 것으로 판단된다. 사출한 BG4400G는 탈크 함량이 10 wt%이므로 기본 원료와 구분하기 위해 PLAT10으로 표기하였다.
Figure 2 및 Table 3에서는 BG4400G를 사출한 PLAT10과 압출한 항균 복합재료들의 펠릿에 대한 TGA 분석 결과를 도시 및 정리하였다. 벤잘코늄염화물과 황화구리(CuS) 분말(100 mesh=149 μm)은 폴리유산의 내열성을 향상시켜 피크 분해온도가 약간 증가하였으나 1,2-알칸디올 혼합물과 세 가지 살생제를 갖는 경우(PLAT10-Mix1.5) 내열성이 약간 감소하였다. 순수한 폴리유산 필름의 경우 DTG 피크가 362.5 oC에 나타났고 ZnO 나노입자 첨가에 의해 피크 온도가 감소한 바 있다.5 차조기 유(perilla essential oil)는 1% 함량에서 상호작용 증가로 인해 분해 피크 온도를 351.9 oC에서 362.9 oC로 크게 상승시켰고19 카바크롤(carvacrol)은 PLA/PBAT(poly- (butylene adipate-co-terephthalate)) 70/30 블렌드 필름에서 폴리유산의 결정화도를 상승시켜 폴리유산의 열안정성을 높였다.18 TiO2 구형 나노입자(nanosphere)도 1, 3 및 5 wt%에서 분해된 폴리유산 증기를 흡수하고 차단하는 효과로 함량에 비례하여 분해온도가 크게 증가하였다.9 벤잘코늄염화물은 1 wt%에서 폴리유산의 내열성이 약간(0.5 oC) 증가하였고 1,2-헥산디올 및 1,2-옥탄디올의 1:1 혼합물만 1 wt%에서 폴리유산의 피크 분해온도를 약간(1.1 oC) 감소시키는 것으로 나타났다. 모노 터르페노이드 페놀(monoterpenoid phenol)인 카바크롤(carvacrol, Tb=237.7 oC)을 PLA/PBAT 블렌드에 첨가한 경우 280 oC 이하에서 증발하여 내열성이 나쁘게 나타났듯이18 1,2-헥산디올 및 1,2-옥탄디올의 1:1 혼합물의 경우도 끓는점이 낮아 이들을 포함하는 항균 복합재료들의 내열성을 낮추는 것으로 판단된다(Figure 2 및 Table 3). CuS 나노입자의 경우는 카라기난(carrageenan)의 열분해속도를 낮추는 것으로 보고되었고32 본 연구에서도 100 메쉬 CuS 분말을 1 wt% 첨가한 경우 폴리유산의 내열성이 약간(3.7 oC) 상승되었다. 3가지 살생제를 1.5 wt% 포함하는 PLA 컴파운드(PLAT10-Mix1.5)에서는 1,2-알칸디올들의 영향이 우세하여 내열성이 기본 수지(PLAT10) 보다 약간 낮게 나타났다.
구입한 그대로의 BG4400G 사출용 펠릿과 압출된 항균 복합소재들의 펠릿 및 사출한 컴파운드들에 대해 DSC 분석을 수행한 결과를 Figure 3 및 Table 4에 나타내었다. 100% 결정의 용융열을 93.7 J/g으로38 정하여 결정화도(χc)를 계산하였다. BG4400G 사출용 펠릿과 압출된 항균 복합소재들의 펠릿을 DSC 분석한 결과 살생제 첨가에 따라 폴리유산의 Tg는 감소하였는데 예상한 대로 1,2-헥산디올 및 1,2-옥탄디올의 1:1 혼합물을 1 wt% 첨가한 경우(PLAT10-HO1)가 PLAT10 보다 8.3 oC 감소한 58 oC로 가장 낮게 나타났다.
기본 수지와 압출물의 경우 저온 결정화(cold crystallization)는 없었으며 융점(Tm)은 살생제 종류에 따라 1,2-알칸디올 혼합물을 사용한 경우만 약간 증가하였고 벤잘코늄염화물 또는 CuS 100 메쉬 분말을 사용한 경우들에선 약간 감소하였다. 세 가지 모두를 사용한 경우는 PLA 융점에 미치는 영향이 서로 상쇄되어 나타났다. 용융열(ΔHm)은 1,2-알칸디올 혼합물을 사용한 경우에서만 기본 수지인 BG4400G의 38.1 J/g에서 24% 감소한 29.0 J/g으로 나타났는데 오히려 융점이 감소한 두 가지 살생제(벤잘코늄염화물과 CuS)를 사용하였을 때는 모두 용융열이 약간 증가하였다. 세 가지를 모두 포함하는 경우도 융점과 마찬가지로 용융열에 대한 효과가 서로 상쇄되어 나타났다. 시프 염기(Sciff’s base)로 변성된 ZrO2는 3 wt% 첨가 시 폴리유산의 자유공간을 증가시켜 Tg를 약 4.1 oC 감소시켰고 Tm 및 결정화도 또한 각각 3.1 oC 및 5.35% 감소시켰다.10 TiO2 구형 나노입자를 이용하여 클로로포름 용액 공정으로 제조된 폴리유산 나노복합재료 필름의 Tg는 거의 변화가 없었고 융점은 1 wt% 및 5 wt%에서만 2 oC 증가하였으며 용융열(즉, 결정화도)은 1 wt% 및 3 wt%에서는 감소하였으나 5 wt%에서는 10% 증가하였다. ZnO 나노입자를 첨가한 클로로포름 용액을 건조시켜 제조한 폴리유산 필름은 1.5 wt%까지 Tg, Tcc, Tm은 순수한 폴리유산과 같았고 결정화도만 12.7%에서 20.4%로 증가하였다.5
가소제로 ATBC(acetyl tributyl citrate) 20 wt%를 용융블렌딩으로 첨가 제조한 100 μm의 폴리유산 필름에서 Tg는 약 18 oC 감소하였으며 키토산을 1 wt% 및 3 wt% 더 첨가할 경우 약간 증가하다가 5 wt%에선 다시 감소하였다.3 저온 결정화온도와 융점도 Tg 변화와 비슷한 경향을 보였으나 용융열은 ATBC 첨가로 약 17% 증가한 46.5%를 보였다가 키토산 첨가량에 비례하여 조금씩 감소하였다.3 폴리유산에 용융블렌딩으로 ATBC 가소제를 10 phr 첨가한 경우에도 융점은 3.1 oC 감소한 169.9 oC를 보였고 용융열(결정화도)은 45.21 J/g(48.25%)에서 49.84 J/g(59.1%)으로 증가하였으며 추가로 키토산을 4차 암모늄화시킨 다음 층간 삽입된 saponite를 1 phr 첨가한 경우 융점은 7.4 oC 더 감소한 162.5 oC를 보였으나 용융열(결정화도)은 52.85 J/g(63.4%)으로 증가하였다.37 이는 ATBC 가소제가 폴리유산의 결정화를 촉진하고 4차 암모늄화 키토산으로 변성된 saponite가 수소결합을 통해 폴리유산의 분자간 상호작용을 파괴하여 융점을 낮추나 뛰어난 기핵 효과를 보인 것으로 설명되었다.37 1,2-알칸디올 혼합물은 압출물에서 키토산 또는 4차 암모늄화 키토산으로 변성된 saponite와 정반대로 결정화는 방해하였고 융점은 약간 상승시켰다.
사출된 폴리유산 기본 수지(PLAT10)와 항균 폴리유산 복합재료들은 금형에서 급냉(분당 100 oC 이상)에 의해 결정화가 미처 완료되지 못해 1st 가열 시 저온결정화 온도(Tcc)의 발열 피크가 나타났으나 자연 냉각(평균 분당 8 oC) 후 2nd 가열 시에는 충분한 결정화로 압출물과 동일하게 저온 결정화가 사라졌다. 2차 가열 시 열적 거동은 냉각 속도에 의존하여 나타나는데 quercertin을 첨가한 PLA에서는 여러 냉각속도(100, 50, 25 oC/min)로 냉각 후 2차 가열 시 저온결정화가 나타나지 않았다.39 본 연구에서 사출물이 압출물과 크게 다른 점은 1,2-알칸디올 혼합물이 사출온도가 200 oC로 다소 높아 양이 많이 줄어든 것으로 인해 특이하게도 1,2-알칸디올 혼합물 1 wt%를 첨가하였던 폴리유산 복합재료의 결정화도가 51.7%로 높게 나타난 것이다. 1,2-알칸디올을 사용한 경우 고온 가공으로 줄어든 살생제로 인해 항균 시험 결과가 나쁠 것으로 예상할 수 있다. 2차 가열은 1차 가열에서 240 oC까지 20 oC/min으로 가열했으므로 내열성이 낮은 유기 살생제는 상당한 양이 증발로 인해 줄어들었을 것으로 판단된다. 2차 가열에서 폴리유산의 융점은 모두 감소하였으나 결정화도는 1차가열 시 보다 오히려 증가하였다. 특이한 점은 세 가지 살생제를 모두 포함하는 항균 PLA 복합재료 사출물(PLAT10-Mix1.5)이 1차 가열 및 2차 가열에서 융점이 가장 낮았으나 결정화도는 각각 50.6% 및 54.1%로 매우 높게 나타난 점이다.
기계적 물성. 폴리유산 기본 수지인 BG4400G를 사출한 PLAT10과 항균 폴리유산 복합재료들의 인장 및 굴곡특성, 충격강도를 Table 5에 정리하였다. 살생제 첨가에 따라 인장강도는 거의 변화가 없었고 인장탄성률은 약간 감소하였으나 신율은 크게 감소하였다. 특히 CuS 100 메쉬 분말의 1 wt% 첨가 시 인장 특성이 가장 크게 감소하였는데 인장강도는 32.6 MPa에서 28.8 MPa로 12%가 감소하였고 인장탄성률은 7.46 GPa에서 6.46 GPa로 13.5% 감소하였으며 신율은 20.1%에서 4.3%로 79% 감소하였다. CuS 분말이 아닌 나노 입자를 한천(agar)에 2.0 wt%까지 첨가한 경우 인장강도는 0.5 wt%에서 순수한 한천 필름보다 36% 증가한 최대값을 보였다가 1.0(23% 증가) 및 2.0 wt%(18% 증가)에선 조금 감소하였으며 인장탄성률도 0.5 wt%에서 27% 증가한 최대값을 보였다가 1.0(21% 증가) 및 2.0 wt%(15% 증가)에선 0.5 wt% 보다 약간 감소하였다. 신율은 CuS 나노입자 0.25 wt%에서 58% 증가한 최대값을 보였다가 0.5(45% 증가), 1.0(30% 증가), 및 2.0 wt%(34% 증가)에선 응집이 증가함에 따라 조금씩 감소하는 경향을 보였다.31 이는 한천과 CuS 나노입자 사이의 강한 분자간 상호작용에 기인할 수 있다고 설명하였다.31 본 연구에서는 CuS 나노입자가 아닌 100 메쉬(149 μm 이하)의 매우 큰 입자가 사용되었으며 수지 또한 한천이 아닌 폴리유산으로 인장특성이 모두 감소한 것으로 판단된다. ZnO 나노입자는 0.5 wt% 첨가 시 인장강도가 순수한 폴리유산의 42.5 MPa에서 58.4 MPa로 37% 증가하였다가 1.0 wt%에서는 54.8 MPa, 1.5 wt%에서는 52.9 MPa로 조금 감소하는 것으로 나타났고 인장탄성률 또한 0.5wt% 첨가 시 순수한 폴리유산의 2.49 GPa에서 2.57 GPa로 3% 증가하였다가 1.0 wt%에서는 2.46 GPa, 1.5 wt%에서는 2.44 MPa로 인장강도와 비슷한 경향을 보였으며 신율은 ZnO 나노입자 1.5 wt% 첨가로 순수한 폴리유산의 4.9%에서 4.4%로 약간 감소하였다.5 폴리유산복합재료의 인장 물성을 증가시키기 위해서는 CuS 100 메쉬 분말 대신 나노입자를 사용할 필요가 있다.
리그닌 나노입자와 셀룰로오스 나노결정을 PLA에 첨가한 나노복합재료에서도 인장 강도와 탄성률이 증가하는 결과를 보였으며 셀룰로오스 나노결정이 강화효과가 더 크게 나타났다.2 벤잘코늄염화물과 1,2-알칸디올 혼합물은 사출용 고분자와 컴파운딩한 연구가 거의 없어 비교할 수 없으나 비슷한 유기 살생제 대한 연구들은 많이 수행되었다. 카바크롤이 PLA/PBAT 블렌드에서 50/50을 제외한 70/30 및 30/70 블렌드에서 2 wt% 및 5 wt% 첨가한 경우 길이방향과 단면방향 모두에서 인장강도는 크게 감소하였고 신율은 30/70 블렌드에서만 카바크롤 첨가량에 비례하여 감소하였고 50/50 블렌드와 70/30 블렌드에서는 두 방향 모두에서 역으로 증가하는 경향을 보였다.18 인장강도가 감소한 이유는 카바크롤의 가소화 효과와 고분자간 상호작용을 낮추는 작용이 원인이고 같은 이유로 신율이 증가한 것으로 고찰하였다.18 인장강도와 인장탄성률은 폴리유산 함량이 증가할수록 커졌는데 인장탄성률은 인장강도와 달리 폴리유산 함량이 적은 30/70 블렌드에서만 카바크롤 첨가량에 비례하여 감소하였으나 50/50 및 70/30 블렌드에서는 카바크롤이 PBAT내에서 PLA 네트웍을 형성시켜 역으로 증가하였다.18 PLA/PBSA(poly(butylene succinate-co-adipate) 블렌드에서도 모노 터르페노이드 페놀(monoterpenoid phenol)인 티몰(thymol, Tb=232 oC)을 3 wt% 또는 6 wt% 첨가한 경우 가소화 효과 및 고분자간 상호작용을 방해하여 인장강도, 인장탄성률은 감소하고 신율은 증가하는 것이 보고된 바 있다.13 유기 살생제의 영향은 주로 가소화 효과와 고분자간 상호작용 방해로 인장강도 및 인장탄성률이 감소하고 신율이 증가한 것과 달리 본 연구에서 벤잘코늄염화물과 1,2-알칸디올 혼합물은 폴리유산 복합재료의 인장강도는 거의 변화시키지 않고 인장탄성률은 약간 감소하고 신율은 크게 감소하는 것으로 나타났다.
PLAT10과 항균 PLA 복합재료들의 굴곡물성도 Table 5에 나타내었다. 굴곡강도는 살생제 첨가에 의해 모두 크게 감소하였는데 CuS 입자가 100 메쉬로 커서 결함으로 작용하여 가장 크게 감소한 것으로 생각된다. 100 메쉬 CuS 분말 1 wt% 첨가 시 굴곡강도가 PLAT10의 63.4 MPa에서 41.9 MPa로 34% 감소하였다. 벤잘코늄염화물과 1,2-알칸디올 혼합물도 가소화 효과 및 고분자간 상호작용 방해로 감소한 것으로 보이며 세 가지를 모두 1.5 wt% 첨가한 PLAT10-Mix1.5도 47.9 MPa로 25% 감소하였다. 반대로 굴곡탄성률은 기본 수지인 PLAT10(3.37 GPa) 보다 약간 증가하였으며 세 가지를 모두 1.5 wt% 첨가한 PLAT10-Mix1.5가 3.64 GPa로 가장 크게 8% 증가하였다.
충격강도 또한 살생제 첨가에 따라 크게 감소하는 경향을 보였고 1,2-헥산디올 및 1,2-옥탄디올의 1:1 혼합물 1 wt% 함량에서 24.7 J/m(33% 감소)로 가장 감소가 작게 나타났다. 벤잘코늄염화물이 1 wt% 첨가된 PLAT10-BC1의 충격강도가 18.8 J/m(49% 감소)로 가장 낮게 측정되었는데 고분자간 상호작용을 방해하거나 탈크의 응집을 일으켜 쉽게 파괴하는 것으로 추정된다. 폴리유산에 용융블렌딩으로 ATBC 가소제를 10 phr 첨가한 경우에 충격강도는 2.95 J/cm2에서 3.67 J/cm2으로 24% 증가하였으며 추가로 키토산을 4차 암모늄화시킨 다음 층간 삽입된 saponite를 첨가한 경우 1 phr에서 최대값(5.23 J/cm2)을 보였다가 3 및 5 phr에서는 첨가량에 비례하여 다소 감소하였다.37
항박테리아 성능. Table 6에 항균 폴리유산 복합재료 4종의 항박테리아 시험 결과를 정리하였다. 벤잘코늄염화물 1 wt%를 포함한 PLAT10-BC1과 세 가지 살생제(벤잘코늄염화물 0.7 wt%, 1,2-헥산디올 및 1,2-옥탄디올의 1:1 혼합물 0.5 wt% 및 CuS 0.3 wt%)를 모두 포함하는 PLAT10-Mix1.5에서만 그램 음성균인 Escherchia coli ATCC 25922(대장균)와 Pseudomonas aeruginosa ATCC 15442(녹농균) 및 그램 양성균인 Staphylococcus aureus ATCC 6538(황색포도상구균) 모두에 대하여 24시간 배양 시 99.9%의 살균력을 보였다. 반면에 1,2-헥산디올 및 1,2-옥탄디올의 1:1 혼합물 1 wt%를 포함하는 PLAT10-HO1 및 CuS 1 wt%를 포함하는 PLAT10-CuS1의 경우는 3종의 세균 모두 죽지 않고 오히려 10배 정도 증가하는 결과를 보였는데 이는 진탕플라스크 배양액으로 방출하는 속도가 느린데 기인하는 것과 살생제 자체의 minimum inhibitory concentration(MIC) 값이 높은 것에 기인하는 것으로 판단된다. 1,2-옥탄디올의 S. aureus 및 S. epidermidis에 대한 MIC 값은 4800 μg/mL(0.48%)로 높고 같은 균들에 대한 1,2-헥산디올의 MIC 값은 89600 ppm(8.96%)으로 매우 높았다.29 또한, 배양액이 수용액이므로 물에 대한 용해도 또한 중요한 인자일 수 있는데 1,2-옥탄디올의 물에 대한 용해도는 3 g/L(0.3%) 정도이고 1,2-헥산디올도 7.5 g/L로 매우 낮은 편이다. CuS는 물에 거의 녹지 않는다. 1,2-헥산디올(Tb=223.5 oC) 및 1,2-옥탄디올(Tb=243 oC)의 경우 내열성이 낮아 압출 및 사출 가공을 통해 반 이상이 증발하여 없어진 것도 추가적인 원인일 수 있다. 반면에 벤잘코늄염화물은 물에 잘 녹고 S. aureus에 대한 MIC가 ≥4 μg/mL 정도로 강력한 살균제이다.40 ZnO를 1.5 wt% 포함하는 폴리유산 필름에서 L. monocytogens는 6시간 이후부터 약간씩 감소하기 시작하였고 E. coli는 3시간 후부터 감소하기 시작하였다.5 ZnO의 살균 기전은 세 가지로 제안되었는데 직접 접촉에 의한 세포 완전성을 파괴하고 Zn2+를 방출하여 DNA 복제와 단백질 합성을 방해하며 reactive oxygene species(ROS)를 형성시켜 박테리아 세포를 파괴하는 것이다.5
항진균 성능. Table 7에 항균 폴리유산 복합재료의 5종 곰팡이에 대한 4주 저항성 시험결과를 정리하였다. 항박테리아 성능과 비슷하게 1,2-알칸디올 혼합물이 3등급(medium growth(30 to 60%))으로 가장 나빴고 벤잘코늄염화물과 CuS 100메쉬 분말은 2등급(light growth(10 to 30%))으로 어느 정도의 곰팡이 저항성을 보였다. 1,2-알칸디올 혼합물과 CuS 100메쉬 분말은 항박테리아 성능이 거의 없었는데 곰팡이 저 항성은 비교적 좋게 나타났다. 항박테리아 시험은 24시간의 비교적 짧은 시간에 이루어져 시험배지로 용출될 시간이 거의 없었으나 곰팡이 저항성은 4주간의 장기간 시험으로 용출이 어느 정도는 이루어져 곰팡이의 성장을 막은 것으로 판단된다.
벤잘코늄염화물 단독으로 1 wt% 함유한 경우 2 등급을 보인 반면 세 가지 살생제(벤잘코늄염화물 0.7 wt%, 1,2-헥산디올 및 1,2-옥탄디올의 1:1 혼합물 0.5 wt% 및 CuS 0.3 wt%)를 모두 포함하는 경우에서 가장 우수한 0 등급을 보였다. 이러한 결과는 항곰팡이 성능에서 세 가지 살생제간 상승효과가 있음을 알 수 있다. 티몰, 카바크롤, 또는 R-카르본을 단독으로 적용한 폴리유산 필름들에서 항곰팡이 성능을 보인 바13,14,18 있으나 살생제간 상승효과는 보고되지 않았다.
항바이러스 성능. Table 8 및 Figure 4에 항균 폴리유산 복합재료 2종(PLAT10-HO1과 PLAT10-Mix1.5)의 Influenza A 바이러스에 대한 시험결과를 정리하였다. 수정된 ISO 21702에 따라 3.2 mm 두께의 5 cm×5 cm 판상시편 5개, 미처리된(untreated) PLAT10, 항균 폴리유산 복합재료 각각을 준비한 다음 MDK 셀을 세포주로 하여 인플루엔자 A 바이러스(Influenza A, H1N1)에 대해 실험을 진행하였다. 1,2-헥산디올 및 1,2-옥탄디올의 1:1 혼합물 1 wt%를 갖는 PLAT10-HO1의 반응시간은 2시간이었고 로그스케일로 0.0414 감소하여 바이러스 감소율은 9.091%로 바이러스 사멸 능력이 매우 낮았고 세 가지 살생제를 모두 합쳐 1.5 wt% 포함하는 PLAT10-Mix1.5의 반응시간은 4시간이었고 로그스케일로 4.699 감소하여 바이러스 감소율은 99.998%로 매우 우수하였다. 항바이러스 능력은 벤잘코늄염화물에 주로 기인하고 1,2-알칸디올 및 CuS 분말에서 악간의 기여는 예상할 수 있으나 벤잘코늄염화물 1 wt% 단독에 대한 결과가 없어 살생제간의 상승효과를 판단할 수 없었다.

|
Figure 1 TGA and DTG thermograms of PLA base resin (BG4400G) and antimicrobial agents. |

|
Figure 2 TGA and DTG thermograms of PLAT10 and antimicrobial PLA composites. |

|
Figure 3 DSC thermograms of PLA base resins and antimicrobial PLA composites. |
|
Figure 4 Antiviral test results of PLAT10-Mix1.5 against Influenza A. |
|
Table 2 TGA Parameters for PLA Base Resin and Antimicrobial Agents |

*The residue was measured as a mass percent at 790 oC. |
|
Table 3 TGA Parameters for PLAT10 and Antimicrobial PLA Composites |

*The residue was measured as a mass percent at 790 oC. |
탈크를 10 wt% 함유한 PLA 복합재료에 살생제로 벤잘코늄염화물, 1,2-헥산디올 및 1,2-옥탄디올의 1:1 혼합물 및 CuS 100메쉬 분말을 단독 또는 혼합적용하여 얻은 항균 복합소재를 다양한 방법으로 분석 및 시험하여 다음과 같은 결론을 얻을 수 있었다.
살생제 첨가에 의해 항균 복합재료의 내열성은 살생제 종류에 따라 다른 거동을 보였는데 벤잘코늄염화물 및 CuS 100메쉬 분말은 약간 증가시켰고 1,2-헥산디올 및 1,2-옥탄디올의 1:1 혼합물은 약간 감소시켰다. 세 가지 살생제(벤잘코늄염화물 0.7 wt%, 1,2-헥산디올 및 1,2-옥탄디올의 1:1 혼합물 0.5 wt% 및 CuS 0.3 wt%)를 모두 포함하는 경우도 내열성이 감소하였다. 기계적 물성에서 인장강도와 신율은 살생제에 의해 크게 감소하였고 인장탄성률은 약간 감소하였으며 굴곡강도도 감소하였으나 굴곡탄성률만 약간 증가하였다. 세 가지 살생제는 단독 첨가 시 모두 기핵 성능을 보여 결정화도는 증가하였고 용융점도 증가하는 경향을 보였는데 세 가지 살생제를 모두 첨가한 경우 융점이 가장 낮게 나타났다.
항균 성능은 벤잘코늄염화물을 포함하는 경우들(단독 또는 혼합)에서 항박테리아(99.9%), 항진균(0 등급-none growth) 성능이 가장 우수하였고 세 가지를 모두 포함하는 폴리유산 복합소재 표면에서 인플루엔자 A를 4시간 접촉시켰을 경우 99.998%의 감소율을 보였다.
거의 모든 살생제는 인체에 독성을 갖고 있어 사용 함량 및 용법에 주의를 기울여야 한다. 가장 우수한 살생제인 벤잘코늄염화물의 경우는 0.1% 농도까지는 안전하게 사용될 수 있다고 보고되었다.41 살생제간 상승작용을 확정하기에는 아직 이르지만 상호간 상승작용으로 인해 살생제의 함량을 줄이면서 항균 성능을 높일 수 있다면 각종 전기 전자 제품의 하우징으로서 항균 폴리유산을 보다 안전하게 적용할 수 있을 것이다. 살생제 종류 및 농도를 최적화한 항균 폴리유산은 많은 전염병을 예방하면서도 친환경적인 소재로 보다 건강한 사회를 만드는 데 크게 기여할 수 있을 것이다.
- 1. Hong, C.; Han, D. The Present Situation and Prediction of Next Generation Biomaterial Poly(lactic acic).Polym. Sci. Technol. 2010, 21, 41-44.
- 2. Yang, W.; Fortunati, E.; Dominici, F.; Giovanale, G.; Mazzaglia, A.; Balestra, G. M.; Kenny, J. M.; Puglia, D. Synergic Effect of Cellulose and Lignin Nanostructures in PLA Based Systems for Food Antibacterial Packaging. Eur. Polym. J. 2016, 79, 1-12.
-

- 3. Râpă, M.; Miteluţ, A. C.; Tănase, E. E.; Grosu, E.; Popescu, P.; Popa, M. E.; Rosnes, J. T.; Sivertsvik, M.; Darie-Niţă, R. N.; Vasile, C. Influence of Chitosan on Mechanical, Thermal, Barrier and Antimicrobial Properties of PLA-biocomposites for Food Packaging. Composites Part B 2016, 102, 112-121.
-

- 4. Srimalanon, P.; Prapagdee, B.; Markpin, T.; Sombatsompop, N. Effects of DCP as a Free Radical Producer and HPQM as a Biocide on the Mechanical Properties and Antibacterial Performance of in situ Compatibilized PBA/PLA Blends. Polym. Test. 2018, 67, 331-341.
-

- 5. Shankar, S.; Wang, L-F.; Rhim, J-W. Incorporation of Zinc Oxide Nanoparticles Improved the Mechanical, Water Vapor Barrier, UV-light Barrier, and Antibacterial Properties of PLA-based Nanocompsite Films. Mater. Sci. Eng. C 2018, 93, 289-298.
-

- 6. Wang, Y.; Hou, J.; Huang, Y.; Fu, Y. Structure-controlled Lignin Complex for PLA Composites with Outstanding Antibacterial, Fluorescent and Photochemical Conversion Properties. Int. J. Biol. Macromol. 2022, 194, 1002-1009.
-

- 7. Zhou, J.; Wang, B.; Xu, C.; Xu, Y.; Tan, H.; Zhang, X.; Zhang, Y. Performance of Composite Materials by Wood Fiber/Poly- dopamine/Silver Modified PLA and the Antibacterial Property. J. Mater. Res. Technol. 2022, 18, 428-438.
-

- 8. Chong, W. J.; Shen, D.; Li, Y.; Trinchi, A.; Pejak, D.; Kyratzis, I.; Sola, A.; Wen, C. Additive Manufacturing of Antibacterial PLA-ZnO Nanocomposites: Benefits, Limitations, and Open Challenges. J. Mater. Sci. Technol. 2022, 111, 120-151.
-

- 9. Salahuddin, N.; Abdelwahab, M.; Gaber, M.; Elneanaey, S. Synthesis and Design of Norfloxacin Drug Delivery System Based on PLA/TiO2 Nanocomposites: Antibacterial and Antitumor Activities. Mater. Sci. Eng. C 2020, 108, 110337, 1-11.
-

- 10. Mr, S. N.; Srinivasan, A. K.; P, K.; S, J. S.; G, A. K. Sciff’s Base (SB) Modified Zirconium Dioxide Reinforced PLA Bio-composite Film for Industrial Packaging Applications. Compos. Commun. 2021, 25, 100750.
-

- 11. Zhou, A.; Zhang, Y.; Zhang, X.; Deng, Y.; Huang, D.; Huang, C.; Qu, Q. Quaternized Chitin/Tannic Acid Bilayers Layer-by-Layer Deposited Poly(lactic acid)/Polyurethane Nanofibrous Mats Decorated with Photoresponsive Complex and Silver Nano- particles for Antimicrobial Activity. Int. J. Biol. Macromol. 2022, 201, 448-457.
-

- 12. Cárdenas-Triviño, G.; Linares-Bermúdez, N.; Núñez-Decap, M. Synthesis and Properties of Bionanocomposites of Polyhydroxy- butyrate-Polylactic Acid Doped with Copper and Silver Nano- particles. Int. J. Polym. Sci. 2019, 2019, 4520927.
-

- 13. Suwanamornlert, P.; Keddongfag, N.; Sane, A.; Chinsirikul, W.; Zou, W.; Chonhenchob, V. Poly(lactic acid)/Poly(butylene-succinate-co-adipate) (PLA/PBSA) Blend Films Containing Thymol as Alternative to Synthetic Preservatives for Active Packaging of Bread. Food Packag. Shelf Life 2020, 25, 100515.
-

- 14. Boonruang, K.; Kerddonfag, N.; Chinsirikul, W.; Mitcham, E. J.; Chonhenchob, V. Antifungal Effect of Poly(lactic acid) Films Containing Thymol and R-(-)-Carvone against Anthranose Pathogens Isolated from Avocado and Citrus. Food Control 2017, 78, 85-93.
-

- 15. Stoleru, E; Dumitriu, R. P.; Munteanu, B. S.; Zaharescu, T.; Tănase, E. E.; Mitelut, A.; Ailiesei, G-L.; Vasile, C. Novel Procedure to Enhance PLA Surface Properties by Chitosan Irreversible Immobilization. Appl. Surf. Sci. 2016, 367, 407-417.
-

- 16. Zhang, M.; Tao, N.; Li, L.; Xu, C.; Deng, S.; Wang, Y. Non-migrating Active Antibacterial Packaging and Its Application in Grass Carp Fillets. Food Packag. Shelf Life 2022, 31, 100786.
-

- 17. Odoňez, R.; Atarés, L.; Chiralt, A. Antibacterial Properties of Cinnamic and Ferulic Acids Incorporated to Starch and PLA Monolayer and Multilayer Films. Food Control 2022, 136, 108678.
-

- 18. Klinmalai, P.; Srisa, A.; Laorenza, Y.; Katekhong, W.; Harnkarnsujarit, N. Antifungal and Plasticization Effects of Carvacrol in Biodegradable Poly(lactic acid) and Poly(butylene adipate terephthalate) Blend Films for Bakery Packaging. LWT-Food Sci. Technol. 2021, 152, 112356.
-

- 19. Wang, D.; Sun, Z.; Sun, J.; Liu, F.; Du, L.; Wang, D. Preparation and Characterization of Polylactic Acid Nanofiber Films Loading Perilla Essential Oil for Antibacterial Packaging of Chilled Chicken. Int. J. Biol. Macromol. 2021, 192, 379-388.
-

- 20. Endo, E. H.; Makimori, R. Y.; Companhoni, M. V. P.; Ueda-Nakamura, T.; Nakamura, C. V.; Dias Filho, B. P. Ketoconazole-loaded Poly-(lactic acid) Nanoparticles: Characterization and Improvement of Antifungal Efficacy in vitro against Candida and Dermatophytes. J. Mycol. Med. 2020, 30, 101003.
-

- 21. Chinavinijkul, P.; Riansuwan, K.; Kiratisin, P.; Srisang, S.; Nasongkla, N. Dip- and Spray-coating of Schanz Pin with PLA and PLA Nanospheres for Prolonged Antibacterial Activity. J. Drug Delivery Sci. Technol. 2021, 65, 102667.
-

- 22. Yao, J.; Liu, J.; Zhi, H.; Tao, H.; Xie, X.; Shi, Q. Surface-modified Polylactic Acid Nanospheres with Chitosan for Antibacterial Activity of 1,2-Benzisothiazolin-3-one. Carbohydr. Polym. 2021, 272, 118406.
-

- 23. Yamamoto, M.; Inokoshi, M.; Tamura, M.; Shimizubata, M.; Nozaki, K.; Takahashi, R.; Yoshihara, K.; Minakuchi, S. Development of 4-META/MMA-TBB Resin with Added Benzalkonium Chloride or Cetylpyridinium Chloride as Antimicrobial Restorative Materials for Root Caries. J. Mech. Behav. Biomed. Mater. 2021, 124, 104838.
-

- 24. Wang, J.; Xue, J.; Dong, X.; Yu, Q.; Baker, S. N.; Wang, M.; Huang, H. Antimicrobial Properties of Benzalkonium Chloride Derived Polymerizable Deep Eutectic Solvent. Int. J. Pharm. 2020, 575, 119005.
-

- 25. Kim, T.-K.; Jang, M.; Hwang, Y. S. Adsorption of Benzalkonium Chlorides onto Polyethylene Microplastics: Mechanism and Toxicity Evaluation. J. Hazard. Mater. 2022, 426, 128076.
-

- 26. Mahajan, R. K.; Nandni, D.; Hassan, P. A.; Aswal, V. K. Microstructure and Mixing Behaviour of Benzalkonium Chloride with Triblock Polymers in Aqueous Medium. Colloid. Surf., A 2011, 386, 1-10.
-

- 27. Roeding J.; Lange, S.; Schmaus G.; Joppe, H.; Pillai, R. Synergistic Mixtures of at least One 1,2 Alkanediol such as 1,2-Hexanediol and 1,2-Octanediol with a Further Compound Having Antimicrobial Properties. US Patent 0265352 A1, 2007.
- 28. Choi, E. Effect of Phenoxyethanol and Alkane Diol Mixture on the Antimicrobial Activity and Antiseptic Ability in Cosmetics. Kor. J. Aesthet. Cosmetol. 2015, 13, 213-220.
- 29. Okugawa, M.; Watanabe, T.; Miura, M.; Konno, H.; Yao, S.; Nonomura, Y. Antibacterial Activity of 1,2-Alkanediol against Staphylococcus aureus and Staphylococcus epidermidis. J. Oleo Sci. 2019, 68, 759-763.
-

- 30. Kabara, J. J.; Orth, D. S. Preservative-Free and Self-Preserving Cosmetics and Drugs Product: The Future. In Preservative-Free and Self-Preserving Cosmetics and Drugs: Principles and Practice, 1st Ed.; Kabara, J. J., Orth, Eds.; D. S.; Cosmetic Science and Technology Series 16; CRC Press: Boca Raton, 1997; pp 243-261.
-

- 31. Roy, S.; Rhim, J-W.; Jaiswal, L. Bioactive Agar-based Functional Composite Film Incorporated with Copper Sulfide Nanoparticles. Food Hydrocolloids 2019, 93, 156-166.
-

- 32. Li, F.; Liu, Y.; Gao, Y.; Zhang, Y.; Zhe, T.; Guo, Z.; Sun, X.; Wang, Q.; Wang, L. Copper Sulfide Nanoparticle-Carrageenan Films for Packaging Application. Food Hydrocolloids 2020, 109, 106094.
-

- 33. Pourhashem, S.; Self, A.; Saba, F.; Nezhad, E. G.; Ji, X.; Zhou, Z.; Zhai, X.; Mirzaee, M.; Duan, J.; Rashidi, A.; Hou, B. Antifouling Nanocomposite Polymer Coatings for Marine Applications: A Review on Experiments, Mechanisms, and Theoretical Studies. J. Mater. Sci. Technol. 2022, 118, 73-113.
-

- 34. Bianculli, R. H.; Mase, J. D.; Schulz, M. D. Antiviral Polymers: Past Approches and Future Possibilities. Macromolecules 2020, 53, 9158-9186.
-

- 35. Doremalen, N.; Bushmaker, T.; Morris, D. H.; Holbrook, M. G.; Gamble, A.; Williamson, B. N.; Tamin, A.; Harcourt, J. L.; Thornburg, N. J.; Gerber, S. I.; Llyod-Smith, J. O.; de Wit, E.; Munster, V. J. Aerosol and Surface Stability of SARS-CoV-2 as Compared with SARS-CoV-1. N. Engl. J. Med. 2020, 382, 1564-1567.
-

- 36. Mouritz, A. P.; Galos, J.; Linklater, D. P.; Landani, R. B.; Kandare, E.; Crawford, R. J.; Ivanova, E. P. Towards Antiviral Polymer Composites to Combat COVID-19 Transmission. Nano Select 2021, 2, 2061-2071.
-

- 37. Xi, X.; Zhen, W.; Bian, S.; Wang, W. Enhancement of Mechanical and Antimicrobial Properties of Thermoplastic Poly(lactic acid)/Quaternized Chitosan-Saponite Nanocomposites. Polym. Korea 2015, 39, 601-610.
-

- 38. Garlotta, D. A Literature Review of Poly(latic acid). J. Polym. Environ. 2001, 9, 63-84.
-

- 39. Park, Y.; Lee, J. Thermal Properties of Poly(lactic acid) Film Containing Antibacterial Quercetin. Polym. Korea 2022, 46, 223-228.
-

- 40. Kemberger-Fischer, I. A.; Krischek, C.; Strommenger, B.; Fiegen, U.; Beyerbach, M.; Kreienbrock, L.; Klein, G.; Kehrenberg, C. Susceptibility of Methicillin-Resistant and -Susceptible Staphylococcus aureus Isolates of Various Clonal Lineages from Germany to Eight Biocides. Appl. Environ. Microbiol. 2018, 84, DOI: 10.1128/AEM.00799-18.
-

- 41. Elder, R. L. Final Report on the Safety Assesment of Benzalkonium Chloride. J. Am. Coll. Toxicol. 1989, 8, 589-625.
- Polymer(Korea) 폴리머
- Frequency : Bimonthly(odd)
ISSN 0379-153X(Print)
ISSN 2234-8077(Online)
Abbr. Polym. Korea - 2025 Impact Factor : 1.0
- Indexed in SCIE
 This Article
This Article
-
2022; 46(5): 684-694
Published online Sep 25, 2022
- 10.7317/pk.2022.46.5.684
- Received on Jun 9, 2022
- Revised on Jul 22, 2022
- Accepted on Aug 1, 2022
 Services
Services
Shared
 Correspondence to
Correspondence to
- Seogjun Kim
-
Department of Chemical Engineering, Kunsan National University, Daehakro 558, Kunsan, Chonbuk 54150, Korea
- E-mail: sjkim@kunsan.ac.kr
- ORCID:
0000-0002-7068-2823















 Copyright(c) The Polymer Society of Korea. All right reserved.
Copyright(c) The Polymer Society of Korea. All right reserved.